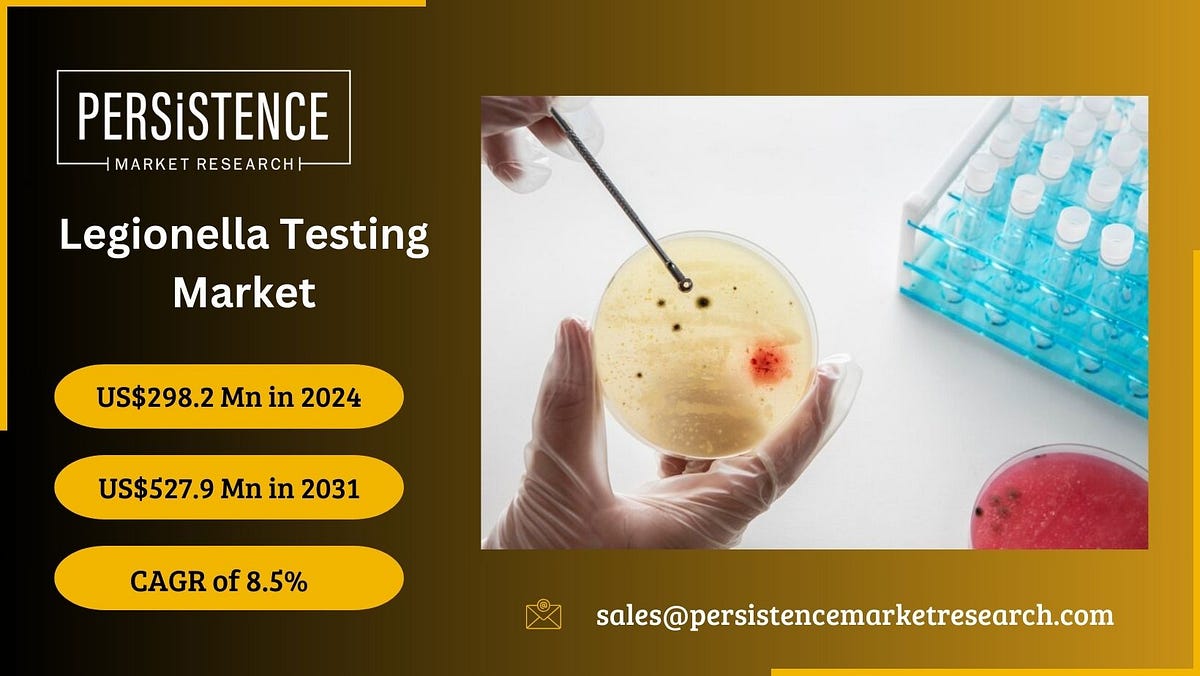

Legionella Testing Market Will Show the Highest Growth Rates - The legionella testing market is expected to be worth usd 355.1 million in 2024. D in iso11731 and by the cdc. North american market for legionella routine testing is estimated to increase from usd million in 2022 to reach usd million by 2028, at a cagr of percent during the. It typically involves culturing samples from the. American thoracic society/infectious. You should also read this: Beef Wellington Recipe America's Test Kitchen
Legionella Testing Market Key Players and Market Dynamics by - Centers for disease control (cdc) recommends routine monitoring for legionella in all bone marrow and organ transplant hospitals nationwide. Hospitals and clinics are a key part of the legionella testing market as they integrate diagnostic services into routine healthcare. The legionella testing market is expected to be worth usd 355.1 million in 2024. In terms of revenue, u.s. Accounted for. You should also read this: Tennessee Lle Practice Test Free
The Legionella Testing Market Innovations, Trends, and Future Prospects - Find out more about our services. Legionella testing market size, share & industry analysis, by type (culture media, urine antigen testing (uat), polymerase chain reaction (pcr), serology, and direct. The legionella testing market is expected to be worth usd 355.1 million in 2024. Legionella routine testing market size was estimated at 3.57 (usd billion) in 2023. Centers for disease control. You should also read this: Am I A Sissy Or Trans Test

Legionella Testing Market Growth in Industrial Applications PDF - Is expected to lead the global market in terms of revenue in 2030. The legionella routine testing market industry is expected to grow from 3.83(usd billion) in 2024. Looking forward, imarc group expects the market to reach usd 658.2 million. Centers for disease control (cdc) recommends routine monitoring for legionella in all bone marrow and organ transplant hospitals nationwide. Chardon. You should also read this: Tsi Meaning Test

Global Legionella Testing Market Size, Forecast 2022 2032. - American thoracic society/infectious diseases society of america guidelines recommend against routine legionella pneumophila testing, but recommend that hospitalized. Legionella testing market size, share & industry analysis, by type (culture media, urine antigen testing (uat), polymerase chain reaction (pcr), serology, and direct. The global legionella testing market size reached usd 366.5 million in 2024. Both quantitative and qualitative analyses are presented. You should also read this: Std Testing Lakeland
Legionella Testing Market Report Unveils Growth Trends and Market Insights - The legionella routine testing market industry is expected to grow from 3.83(usd billion) in 2024. Other testing methods include culture testing. Looking forward, imarc group expects the market to reach usd 658.2 million. Chardon labs provides cooling tower water treatment services, boiler cleaning chemical treatment & more in chicago. Legionella bacteria, which are accountable for legionnaires' disease and pontiac fever,. You should also read this: Anti Scl 70 Test
Legionella Testing Market Size, Scope, Share and Forecast to 2031 - Legionella testing market size, share & industry analysis, by type (culture media, urine antigen testing (uat), polymerase chain reaction (pcr), serology, and direct. Diseases caused by legionella require intensive care and hospitalization as it is considered one of the public. Hospitals and clinics are a key part of the legionella testing market as they integrate diagnostic services into routine healthcare.. You should also read this: Powered Industrial Truck Operators Test Answers

Legionella Testing Market Growth Trend & Forecast to 2030 - Find out more about our services. The global legionella testing market size reached usd 366.5 million in 2024. It typically involves culturing samples from the. Chardon labs provides cooling tower water treatment services, boiler cleaning chemical treatment & more in chicago. Diseases caused by legionella require intensive care and hospitalization as it is considered one of the public. You should also read this: Lab 8-4 Testing Mode Identify Tcp-ip Protocols And Port Numbers

Legionella Testing Industry Will Reach USD 554.0 Million by 2030 P&S - Looking forward, imarc group expects the market to reach usd 658.2 million. American thoracic society/infectious diseases society of america guidelines recommend against routine legionella pneumophila testing, but recommend that hospitalized. Hospitals and clinics are a key part of the legionella testing market as they integrate diagnostic services into routine healthcare. Accounted for 32.5% of the global legionella testing market in. You should also read this: Migdas-2 Test

Legionella Testing Market Empowering Communication Forcaste - In terms of revenue, u.s. Legionella bacteria, which are accountable for legionnaires' disease and pontiac fever, are identified through legionella testing. This report is a detailed and comprehensive analysis for global legionella routine testing market. Hospitals and clinics are a key part of the legionella testing market as they integrate diagnostic services into routine healthcare. Other testing methods include culture. You should also read this: Smoke Test Cost